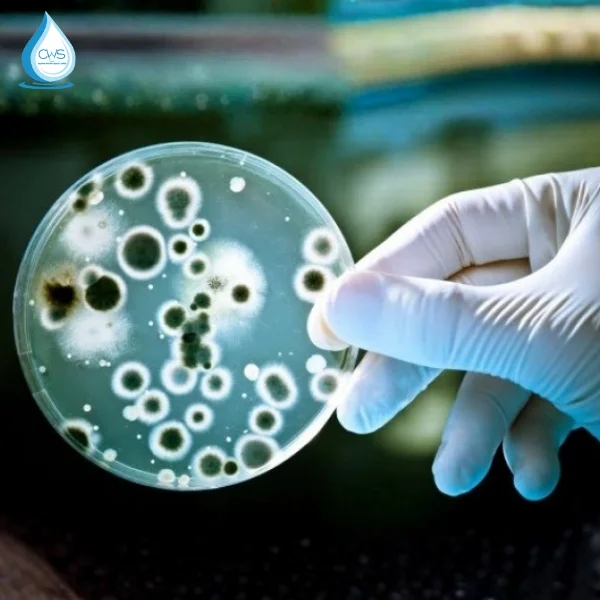

Lõi lọc nước Truliva là phụ kiện không thể thiếu giúp máy lọc nước vận hành ổn định. Và duy trì chất lượng nước đạt chuẩn an toàn cho sức khỏe. Việc thay thế lõi lọc Truliva định kỳ không chỉ giúp loại bỏ hiệu quả vi khuẩn, tạp chất, kim loại nặng tồn dư trong nước. Mà còn bảo vệ hệ thống máy, kéo dài tuổi thọ thiết bị. Và đảm bảo nguồn nước tinh khiết mỗi ngày cho cả gia đình. Đặc biệt, với các dòng máy hiện đại sử dụng công nghệ lọc trực tiếp. Bộ lõi đóng vai trò như một “lá phổi” lọc sạch mọi tác nhân gây hại trước khi nước đến tay người dùng.
Mua lõi lọc nước Truliva chính hãng tại Clean Water Solutions ngay hôm nay. Để yên tâm sử dụng nước sạch chuẩn chất lượng và bảo vệ sức khỏe người thân lâu dài.
Lõi Lọc Nước Truliva – Tinh Hoa 25 Năm Kế Thừa Và Phát Triển
Lõi lọc nước Truliva không phải là một sản phẩm mới xuất hiện. Mà là kết quả của sự kế thừa tinh hoa từ những thương hiệu hàng đầu thế giới trong ngành lọc nước. Với hơn 25 năm kinh nghiệm nghiên cứu và phát triển. Truliva đã tạo ra hệ thống lõi lọc nguyên khối thế hệ mới.
Thiết kế này mang tính đột phá khi toàn bộ vật liệu lọc được đúc kín trong một thân lõi duy nhất. Giúp ngăn chặn triệt để tình trạng nhiễm khuẩn chéo từ môi trường bên ngoài trong suốt quá trình vận hành hay khi thay thế lõi mới.
Sự tinh tế trong thiết kế của lõi lọc nước Truliva còn thể hiện qua đầu nối dạng Twist and Turn (Xoay và Vặn). Đây là một cải tiến hướng tới người dùng. Khi chỉ cần một thao tác vặn và xoay đơn giản là có thể tháo lắp lõi.
Cơ chế này giúp cho kể cả phụ nữ, người lớn tuổi. Hay những người không am hiểu về kỹ thuật cũng có thể tự thay thế lõi tại nhà một cách dễ dàng. Mà không cần sự hỗ trợ của kỹ thuật viên chuyên nghiệp. Giúp tiết kiệm thời gian và chi phí bảo trì đáng kể.

Khả năng tương thích và kế thừa từ Unilever Pureit
Một điểm cực kỳ ấn tượng là lõi lọc nước Truliva hoàn toàn tương thích và có thể sử dụng thay thế cho dòng máy Unilever Pureit Delica. Điều này xuất phát từ việc thương hiệu Truliva được phát triển dựa trên chính triết lý thiết kế và công nghệ của Unilever.
Đặc biệt, các dòng máy lọc nước Unilever Pureit Delica âm tủ bếp. Sử dụng lõi đúc thế hệ mới có thể dùng chung bộ lõi lọc nước Truliva mà vẫn đảm bảo hiệu suất lọc tối ưu. Đây là giải pháp thay thế linh hoạt và tiết kiệm cho những khách hàng đang sử dụng model Pureit. Nhưng mong muốn trải nghiệm công nghệ lọc tiên tiến nhất từ Truliva. Cũng như là giải pháp thay thế tiện lợi, linh động về lâu dài.
Mặc dù một hệ thống máy lọc nước Truliva thường chỉ gồm từ 2 đến 3 lõi vật lý tùy theo model. Nhưng bên trong chúng lại được tích hợp một quy trình xử lý nước vô cùng phức tạp. Với 5 đến 7 bước lọc chuyên sâu.
Việc tích hợp nhiều bước lọc trong một lõi giúp tối ưu hóa quá trình làm sạch nước. Loại bỏ từ rỉ sét, bùn đất đến các vi sinh vật siêu nhỏ. Kết hợp cùng đèn UV diệt khuẩn ở bước cuối cùng. Hệ thống này có khả năng loại bỏ tới 99.9% vi khuẩn và virus. Mang lại sự tinh khiết tuyệt đối cho nguồn nước uống trực tiếp.

Một Số Thông Tin Về Chất Lượng Lõi Lọc Nước Truliva
Khi lựa chọn lõi lọc nước Truliva. Người tiêu dùng không chỉ mua một sản phẩm vật lý. Mà còn đang mua sự cam kết về chất lượng từ một thương hiệu có bề dày lịch sử. Chất lượng của bộ lõi này được kiểm chứng bởi quy trình sản xuất nghiêm ngặt. Cũng như những chứng nhận an toàn thực phẩm khắt khe nhất hiện nay. Đảm bảo không có bất kỳ rủi ro nào về hóa chất thôi nhiễm trong quá trình lọc.
Được nghiên cứu và phát triển bởi thương hiệu Truliva
Thương hiệu Truliva có một lý lịch vô cùng ấn tượng khi từng trực thuộc thương hiệu Unilever. Và được biết đến rộng rãi thông qua các sản phẩm máy lọc nước Pureit Delica danh tiếng.
Sau khi tách ra và hoạt động độc lập dưới sự quản lý của tập đoàn Qinyuan. Một trong những nhà sản xuất thiết bị lọc nước lớn nhất thế giới. Các nhà nghiên cứu đã liên tục cải tiến lõi lọc nước Truliva để phù hợp hơn với đặc thù nguồn nước tại các khu vực đô thị đang phát triển.

Sự am hiểu sâu sắc về thói quen sử dụng nước của người Á Đông đã giúp Truliva tạo ra những bộ lõi có khả năng xử lý nước ưu việt. Nhưng vẫn giữ được độ bền cao.
Xem thêm các sản phẩm thương hiệu Truliva ngay tại đây
máy lọc nước TrulivaXem tất cả
lõi lọc nước trulivaXem tất cả
Các chứng nhận về chất lượng và sức khỏe của lõi lọc
Để khẳng định vị thế trên thị trường quốc tế. Lõi lọc nước Truliva đã vượt qua hàng loạt các đợt kiểm định. Và đạt được các chứng nhận danh giá:
- Chứng nhận WQA: Đây là con dấu vàng của Hiệp hội Chất lượng Nước quốc tế. Bảo chứng cho khả năng xử lý các tạp chất gây ô nhiễm một cách hiệu quả và tin cậy.
- Chứng nhận của Bộ Y Tế – Viện Pasteur: Nước đầu ra từ lõi lọc nước Truliva đạt chuẩn QCVN 6-1:2010/BYT dành cho nước uống trực tiếp. Đây là tiêu chuẩn cao nhất tại Việt Nam, đảm bảo nước an toàn như nước đóng chai.
- Chứng nhận SGS: Đảm bảo toàn bộ vật liệu vỏ lõi và vật liệu lọc được làm từ nhựa cao cấp không chứa BPA. Không gây độc hại cho sức khỏe khi tiếp xúc lâu dài với nguồn nước.

Những Ưu Điểm Vượt Trội Của Lõi Lọc Nước Truliva Chính Hãng
Lõi lọc nước Truliva không chỉ đơn thuần là bộ phận thay thế. Mà nó sở hữu những công nghệ độc quyền giúp định nghĩa lại khái niệm về nước sạch tại vòi. Những ưu điểm này giúp Truliva khác biệt hoàn toàn so với các dòng lõi lọc thô truyền thống trên thị trường. Mang lại giá trị sử dụng lâu dài và sự an tâm tuyệt đối cho khách hàng của Clean Water Solutions.
Thiết kế nguyên khối chống nhiễm khuẩn
Thiết kế lõi lọc đúc nguyên khối (Integrated Filter) của Truliva mang lại những ưu điểm vượt trội về độ an toàn và tính tiện dụng. Lõi lọc được đúc kín hoàn toàn tại nhà máy. Giúp giảm thiểu tối đa các khớp nối và cút nối rời rạc. Điều này mang lại hai lợi ích lớn:
- Chống rò rỉ nước tuyệt đối: Việc loại bỏ các điểm tiếp xúc lỏng lẻo giúp hệ thống vận hành cực kỳ an toàn. Không lo rò rỉ nước gây hỏng tủ bếp hay sàn nhà.
- Ngăn chặn tái nhiễm khuẩn: Do thiết kế khép kín hoàn toàn. Lõi lọc nước Truliva không tiếp xúc với môi trường bên ngoài trong suốt quá trình vận chuyển. Điều này ngăn chặn vi khuẩn, bụi bẩn hay nấm mốc xâm nhập vào bên trong vật liệu lọc. Đảm bảo nguồn nước đầu ra luôn tinh khiết 100%.
- Thay thế nhanh (Quick Change): Chỉ với vài giây xoay nhẹ. Người dùng đã có thể hoàn tất việc bảo trì mà không cần bất kỳ dụng cụ chuyên dụng nào.

Công nghệ TRUE-TECH độc quyền
Công nghệ TRUE-TECH (hay còn gọi là TRU-TECH) là “trái tim” trong các lõi lọc của Truliva. Giúp nâng cấp hiệu suất lọc lên một tiêu chuẩn mới. Công nghệ này cho phép lõi lọc nước Truliva loại bỏ đến 99,9% vi khuẩn, vi-rút. Và đặc biệt là các kim loại nặng có kích thước siêu nhỏ mà các màng lọc thông thường dễ bỏ sót.
Phiên bản TRUE-TECH PRO mới nhất thậm chí có khả năng lọc sạch tới 104 loại chất ô nhiễm khác nhau. Từ dư lượng thuốc trừ sâu đến các gốc hóa học công nghiệp phức tạp.

Bên cạnh khả năng làm sạch, TRUE-TECH còn tối ưu hóa tốc độ dòng chảy. Các máy lọc sử dụng lõi lọc nước Truliva có thể đạt tốc độ lọc ấn tượng từ 1,5 đến 2,5 lít/phút.
Nhờ tốc độ xử lý nhanh. Hệ thống cung cấp nước tươi (fresh water) trực tiếp tại vòi mà không cần bình áp tích trữ. Điều này loại bỏ hoàn toàn nguy cơ nước bị “ôi” hoặc tái nhiễm khuẩn khi để lâu ngày trong bình chứa. Một vấn đề thường gặp ở các máy lọc RO đời cũ.
Độ bền vượt trội và tính đa chức năng
Sự kết hợp giữa công nghệ TRUE-TECH và màng lọc RO chất lượng cao. Giúp lõi lọc nước Truliva có độ bền vượt trội. Công suất lọc tổng của bộ lõi thường đạt mức 7.500L. Đủ sức phục vụ nhu cầu nước uống và nấu ăn liên tục cho gia đình đông người hoặc các văn phòng nhỏ.
Trong điều kiện nước máy tiêu chuẩn và được bảo dưỡng lõi thô định kỳ. Màng RO của Truliva có thể duy trì hiệu suất ổn định kéo dài nhiều năm. Giúp tối ưu chi phí vận hành cho người dùng.

Mỗi lõi lọc nước Truliva còn là một thiết bị đa chức năng. Thay vì phải lắp đặt 7-10 lõi lọc rườm rà như trước. Truliva tích hợp nhiều tầng vật liệu (như sợi PP, than hoạt tính, màng RO, lõi hậu carbon) vào trong 2-3 lõi đúc.
Việc giảm bớt số lượng lõi không chỉ giúp bảo vệ môi trường bằng cách giảm rác thải nhựa. Mà còn giúp người dùng dễ dàng hơn trong việc ghi nhớ và thay thế lõi định kỳ. Tránh nhầm lẫn giữa các loại lõi lọc khác nhau.
Tầm Quan Trọng Của Việc Thay Thế Lõi Lọc Nước Truliva Đúng Hạn
Việc thay lõi lọc nước Truliva đúng hạn không chỉ đơn thuần là công việc bảo trì máy móc. Mà đó chính là yếu tố sống còn để bảo vệ sức khỏe cho cả gia đình bạn. Nhiều khách hàng thường có tâm lý “nước còn chảy là lõi còn dùng được”. Nhưng đây là một quan niệm sai lầm và tiềm ẩn nhiều rủi ro nghiêm trọng về sức khỏe và kinh tế.

Ngăn chặn sự tích tụ độc tố và vi khuẩn
Sau một thời gian dài hoạt động. Các tạp chất, kim loại nặng và bùn đất bị giữ lại sẽ tích tụ dày đặc bên trong lõi lọc nước Truliva. Khi vượt quá giới hạn chịu tải. Các lớp cặn bẩn này có thể trở thành môi trường lý tưởng cho vi khuẩn phát triển ngược.
Lúc này, lõi lọc không còn đóng vai trò làm sạch. Mà lại trở thành nguồn gây “ô nhiễm thứ cấp”. Uống nước từ lõi lọc quá hạn sẽ trực tiếp đưa các chất độc hại này vào cơ thể. Gây nguy cơ mắc các bệnh đường ruột cấp tính hoặc tích tụ độc tố trong gan và thận về lâu dài.
Đảm bảo sức mạnh của công nghệ TRUE-TECH
Công nghệ TRUE-TECH độc quyền chỉ có thể phát huy tối đa sức mạnh loại bỏ 104 loại chất ô nhiễm. Khi và chỉ khi các lớp vật liệu lọc còn trong trạng thái hoạt động tốt. Khi lõi quá hạn, khả năng thẩm thấu và hấp phụ hóa học suy giảm rõ rệt.
Các độc tố siêu nhỏ như Clo dư hay các hợp chất hữu cơ dễ bay hơi có thể lọt qua vòi uống. Làm mất đi tính an toàn tuyệt đối mà máy lọc mang lại. Thay lõi lọc nước Truliva đúng hạn. Chính là cách duy nhất để duy trì “lá chắn” bảo vệ sức khỏe vững chắc nhất.

Duy trì chất lượng nước tươi và bảo vệ máy
Hệ thống lọc trực tiếp của Truliva giúp nước luôn ngọt mát và tươi mới. Tuy nhiên, nếu lõi lọc bị đóng cặn nặng. Tốc độ dòng chảy sẽ giảm sút đáng kể. Nước có thể xuất hiện mùi hôi tanh khó chịu do clo không được xử lý triệt để.
Hơn thế nữa, việc thay lõi thô định kỳ sẽ giúp giảm tải cho màng RO TRUE-TECH vốn có giá trị cao nhất trong hệ thống. Nếu để lõi thô bẩn quá lâu, máy bơm phải hoạt động liên tục với áp suất lớn. Để đẩy nước qua khe lọc bị tắc, dễ gây cháy bơm và hỏng hóc các linh kiện điện tử. Dẫn đến chi phí sửa chữa vô cùng tốn kém.

Thời Gian Thay Thế Lõi Lọc Nước Truliva Theo Khuyến Nghị
Để đảm bảo máy lọc nước Truliva luôn vận hành trong trạng thái tốt nhất. Clean Water Solutions khuyến cáo khách hàng nên tuân thủ lịch trình thay thế lõi như sau:
- Lõi chức năng (PCP/CTO): Nên thay thế sau khoảng 3 – 6 tháng tùy thuộc vào chất lượng nước đầu vào tại khu vực sinh sống. Nếu nước có nhiều phèn hoặc cặn, thời gian thay có thể ngắn hơn.
- Màng RO TRUE-TECH: Cần kiểm tra và thay thế khi máy có cảnh báo hoặc sau chu kỳ 24 – 36 tháng. Một số model cao cấp trong điều kiện nước lý tưởng có thể kéo dài tuổi thọ hơn. Nhưng việc kiểm tra định kỳ là bắt buộc để đảm bảo chất lượng nước.

Một điểm cộng lớn là trên thân máy và ngay trên vòi lấy nước của máy lọc nước Truliva. Đều được tích hợp tính năng đèn báo thay lõi thông minh. Khi đèn chuyển màu báo hiệu. Khách hàng cần liên hệ ngay đơn vị cung cấp để mua lõi lọc nước Truliva chính hãng thay thế. Tránh việc sử dụng lõi đã hết tác dụng lọc.
Đâu Là Địa Chỉ Uy Tín Mua Lõi Lọc Nước Truliva Chính Hãng
Hiện nay trên thị trường có không ít các đơn vị cung cấp lõi lọc giả, nhái với giá thành rẻ. Nhưng chất lượng vật liệu lọc không đảm bảo. Để bảo vệ máy và sức khỏe gia đình, việc tìm kiếm một địa chỉ uy tín là điều tiên quyết.
Clean Water Solutions (CWS) tự hào là đơn vị chuyên cung cấp các giải pháp lọc nước nhập khẩu hàng đầu. Đồng thời là địa chỉ phân phối các dòng phụ kiện, lõi lọc nước Truliva chính hãng. Với đầy đủ giấy tờ chứng nhận.
Tại Clean Water Solutions, chúng tôi cam kết:
- Sản phẩm 100% chính hãng: Lõi lọc nguyên seal, có mã vạch kiểm tra từ nhà sản xuất Truliva.
- Dịch vụ chuyên nghiệp: Đội ngũ kỹ thuật viên am hiểu sâu về công nghệ lọc TRUE-TECH. Hỗ trợ thay thế nhanh chóng và thẩm mỹ.
- Giao hàng toàn quốc: Chúng tôi hỗ trợ giao hàng tận nơi trên toàn lãnh thổ Việt Nam. Đặc biệt là dịch vụ lắp đặt nhanh trong vòng 2h tại khu vực TPHCM.
- Nhắc lịch thay lõi: Hệ thống quản lý khách hàng thông minh của CWS sẽ tự động nhắc nhở bạn khi đến hạn thay lõi lọc nước Truliva. Giúp bạn hoàn toàn an tâm trong suốt quá trình sử dụng.
Đừng để nguồn nước bẩn ảnh hưởng đến chất lượng cuộc sống của gia đình bạn. Hãy liên hệ ngay với Clean Water Solutions để được tư vấn và đặt mua bộ lõi lọc nước Truliva chính hãng với mức giá cạnh tranh nhất thị trường. Chúng tôi luôn sẵn sàng đồng hành cùng bạn trên hành trình mang nguồn nước sạch và tinh khiết đến mọi nhà!
Công ty TNHH Clean Water Solutions
Hotline – Zalo: 0932.69.83.86
Trụ sở chính
- Showroom HCM: 32 Trần Lựu, Phường Bình Trưng, TP. Thủ Đức, TP. HCM
Chi nhánh
HÀ NỘI, ĐÀ NẴNG, NHA TRANG, CẦN THƠ, ĐÀ LẠT
- Website: maylocnuoccaocap.com maylocnuoccaocap.com.vn cleanwatersolutions.vn
- Fanpage: https://www.facebook.com/maylocnuoccaocap.fan
- Youtube: https://youtu.be/wQ2Hy9wZ8gw
- Tiktok: https://www.tiktok.com/@maylocnuoccaocap1

CWS – Đơn vị cung cấp thiết bị lọc nước chính hãng tại HCM























